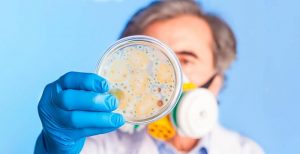

Riscos-ocupacionais-ou-biológicos
- Home
- Riscos-ocupacionais-ou-biológicos
Entre em Contato
Endereço: Av. Aratãs, 164
Moema - São Paulo, SP - Brasil
Telefone: +55 (11) 5542.5855 ou 5095.5353
WhatsApp: +55 (11) 98919.6084
contato@labordental.com.br
Loja Online
Moema - São Paulo, SP - Brasil
Telefone: +55 (11) 5542.5855 ou 5095.5353
WhatsApp: +55 (11) 98919.6084
contato@labordental.com.br
Loja Online
Últimas Notícias:
- Embaixadores FKG02 ago 2024 1
- Comunicado Labordental – Resinas Solidex e Ceramage17 maio 2024 2
- Campanha Solidária & Indústrias Parceiras13 maio 2024